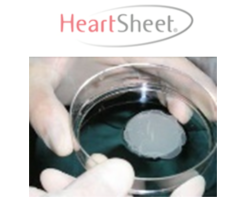
ハートシート

阪大拠点支援の成果
支援シーズの成果:製造販売承認及び薬事承認取得製品
製造販売承認品目
| 再生医療等製品 | オキュラル | 角膜上皮幹細胞疲弊症に対する自己口腔粘膜上皮細胞シート移植治療 |
|---|---|---|
| リハート | ||
| e-Bone | 骨形成能を有するプラズマアミン修飾人工骨の開発 | |
| 医薬品 | ラパリムスゲル | mTOR阻害剤外用薬による結節性硬化症皮膚病変治療 |
| 医療機器 | アキュリオ変形矯正システム | カスタムメイドの手術ガイドと骨接合プレートを用いた上肢骨変形矯正 |
| リモハブCR U | 在宅で受ける心臓リハビリテーション! 遠隔心臓リハビリシステム | |
| 歩行分析計Dr Walkie Plus | 整形外科医が開発した全ての人のための歩行分析計 | |
| GLEIAスティックCRP・GLEIAベースCRP | 電気化学免疫センサー及び小型迅速計測器の開発 |
薬事承認品目
| 再生医療等製品 | ハートシート | 重症心不全に対する自己筋芽細胞シート移植治療 |
|---|---|---|
| 遺伝子治療 | コラテジェン | 慢性動脈閉塞性に対するHGFプラスミド遺伝子治療 |
| 医療機器 | バイアユーアール | 妊治療のための子宮着床能評価装置の開発 |
支援シーズの成果
製造販売承認取得 14製品
2025年7月現在、他機関シーズ1件を含む
再生医療等製品
重症心不全に対する自己筋芽細胞シート移植治療
ハートシート
- 薬事承認
- 2015.9.18
- 保険収載
- 2015.11.26
大阪大学心臓血管外科 ⇒ テルモ(株)
角膜上皮幹細胞疲弊症に対する自己口腔粘膜上皮細胞シート移植治療
オキュラル

- 薬事承認
- 2021.5.24
- 保険収載
- 2021.12.1
大阪大学眼科 ⇒(株)ジャパン・ティッシュエンジニアリング
慢性動脈閉塞性に対するHGFプラスミド遺伝子治療
コラテジェン

- 薬事承認
- 2019.3.26
- 保険収載
- 2019.9.4
大阪大学臨床遺伝子治療学 ⇒ 田辺三菱製薬(株)
医薬品・体外診断用医薬品
mTOR阻害剤外用薬による結節性硬化症皮膚病変治療
ラパリムスゲル

- 薬事承認
- 2019.3.26
- 保険収載
- 2019.9.4
- 海外承認
- 米国2022.3.22、
中国2023.3.28、
欧州2023.5.15、
英国2023.9.1
大阪大学皮膚科 ⇒ ノーベルファーマ(株)
電気化学免疫センサー及び小型迅速計測器の開発
GLEIAスティックCRP
GLEIAベースCRP

- 薬事承認
- 2022.5.18
- 保険収載
- 2022.5.23
大阪大学工学研究科 ⇒ (株)イムノセンス
医療機器
カスタムメイドの手術ガイドと骨接合プレートを用いた上肢骨変形矯正
アキュリオ変形矯正システム

- ガイド:
- 薬事2013.6.21
保険2014.1.1
- プレート:
- 薬事2014.2.28
保険2014.7.1
- システム:
- 薬事2019.11.13
保険2021.6.1
大阪大学整形外科⇒帝人ナカシマメディカル(株)
不妊治療のための子宮着床能評価装置の開発
バイアユーアール

- 薬事承認
- 2023.1.19
大阪大学産婦人科⇒TSSメディカル(株)
在宅心不全患者のRSTを遠隔モニタリングすることにより、心不全の増悪を早期に検知
心不全遠隔モニタリングシステム

- 薬事承認
- 2024.8.23
大阪大学心臓血管外科 ⇒ハートラボ(株)
遠隔心臓リハビリテーションシステム
リモハブ CR U

- 薬事承認
- 2025.6.23
大阪大学循環器内科 ⇒ (株) リモハブ
骨形成能を有するプラズマアミン修飾人工骨の開発
e=Bone

- 薬事承認
- 2023.1.19
- 保険収載
- 2023.3.1
大阪大学整形外科⇒(株)アイメディックMMT



